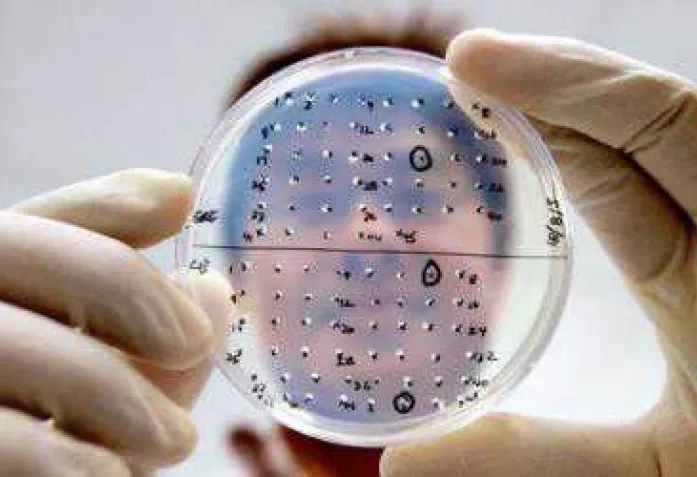

Его производитель, фармацевтическая компания «Новартис», отказывается бесплатно делиться им с бедными странами.
|
Novartis, l'inventeur du vaccin contre la grippe A (H1N1), refuse de donner gratuitement des doses aux pays pauvres.
Как уже известно уже во всем мире, Всемирная организация здравоохранения официально объявила о начале
пандемии гриппа А (впервые за 40 лет). Опасность инфицирования поднялась до максимального - шестого - уровня.
А несколько дней назад крупнейший производитель фармацевтической продукции, швейцарский концерн «Новартис», официально сообщил радостную новость: готовы первые партии вакцины против свиного гриппа. С сентября он перепрофилирует свои заводы в Германии, Великобритании и Италии на производство вакцины против нового гриппа, которая будет выпускаться объемом 150-200 миллионов доз в год.
Новость о создании вакцины вызвала бурные дебаты. Вернее, не само открытие, о отказ фирмы предоставить по просьбе Всемирной организации здравоохранения бесплатную вакцину для отправки в бедные и развивающиеся страны. Здоровье жителей там более хрупкое, чем у населения высокоразвитых индустриальных держав, и в случае эпидемии именно бедные страны страдают больше всего. Поэтому слово «солидарность» не должно быть пустым звуком - надеется глава ВОЗ Маргарет Чан.
Конкуренты показывают себя более щедрыми: так фирма GlaxoSmithKline, номер 2 в фармацевтической индустрии, высказала свою готовность выделить не менее 50 миллионов доз вакцины для отправки в нуждающиеся в ней страны. Другие производители предлагают отдать бесплатно на 10% своей продукции вакцины.
Директор «Новартиса»
Даниэль Вазелла (самый высокооплачиваемый менеджер Европы), объясняет скупость своей компании тем, что уже сегодня значительная часть запланированной продукции против вируса H1N1 зарезервирована правительствами. Только руководство США заказало вакцины на 289 миллионов долларов. Стоимость одной дозы вакцины для прививки против свиного гриппа, по оценкам Васеллы, составит от 11 до 16 франков. Основная масса ее должна поступить на рынок в конце года.

![]()

![]()

![]()